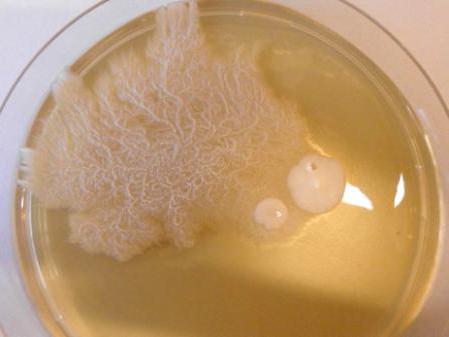
image

Так устроен мир, что каждого из нас окружают тысячи микроскопических существ. Невооруженным глазом мы их не видим, но соприкасаемся с ними ежеминутно. Одни «невидимки» нам помогают, другие убивают, а третьи могут приносить, и вред, и пользу. Дрожжеподобные грибы рода Кандида являются как раз такими микробами, которые не мешают нам жить счастливо, но в определенных ситуациях начинают вести себя агрессивно, вызывая заболевание кандидоз или молочницу. Потому что эти микроорганизмы не всегда приносят вред, их называют условно-патогенными. Всего открыто 186 видов грибов из рода Кандида, но опасны лишь два десятка видов. О них пойдет речь в данной статье.
Род грибов Кандида: характерные особенности
Кандиды относятся к роду дрожжей. Большинство их видов являются совершенно безвредными, живут в теле чайного гриба, в кефире, в других кисломолочных продуктах, а также в ЖКТ человека, являя собой часть микрофлоры здорового кишечника. Грибы рода Кандида являются аэробами, то есть, ведут активную жизнь при наличии кислорода. Они могут существовать в двух формах – дрожжевой и мицеллярной.
От других диморфных созданий грибы рода Кандида отличаются тем, что могут находиться в теле своего хозяина сразу в двух своих формах, а не менять их в зависимости от температуры среды.
Важное свойство кандид – они умеют ферментировать мальтозу и глюкозу.
Заболевание кандидоз, согласно последним исследованиям, вызывают примерно 20 видов этих грибов, а наиболее опасными являются C.Albicans (60%) и C.Tropicalis (20%). Остальные 18 видов распространены менее широко и значительного влияния на уровень заболеваемости кандидозом не оказывают.
Краткое описание патогенных видов
Наиболее широко встречаются грибы рода Кандида, называющиеся C.Albicans. Их носителями являются примерно 8 человек из 10. В основном эти грибы попадают в организм младенца при рождении и живут, не доставляя неудобств, в ротовой полости, в пищеводе и в кишечнике. У женщин они также являются частью микрофлоры влагалища. Именно этот вид кандид чаще всего повинен в возникновении кандидоза.
Второй опасный вид называется C.Tropicalis. Эти грибы способны проникать в кровь и с ее помощью заселять периферические органы. Последние исследования выявили особенность Кандиды C.Tropicalis работать в тандеме с Serratia marcescens и с Escherichia coli, и приводить к болезни Крона.
Не очень распространены, но считаются самыми опасными дрожжевые грибы рода Кандида вида C.Krusei. Они устойчивы к лекарству «Флуконазол», использующемуся при лечении грибковых инфекций, поэтому важно правильно дифференцировать вид патогенного грибка, поразившего больного.
Грибы Кандида вида C.Glabrata считались непатогенными. Они существуют только в дрожжевой форме и размножаются только почкованием. Чаще всего Кандида Глабрата обнаруживается на мочевых катетерах, где она образует тонкие биопленки. Этот гриб вызывает урогенитальный кандидоз.
Кандида вида C.Parapsilosis часто становится причиной сепсиса. Она способна инфицировать раны, особенно если в них попадают инородные предметы.
Виды грибов C.Rugosa и C.Lusitaniae и другие из рода Кандида встречаются крайне редко. Например, C.Lusitaniae в период с 1979 по 1990 года был выявлен только у 30 пациентов.
Пути инфицирования
Условно – патогенные дрожжеподобные грибы рода Кандида в процессе эволюции выработали механизмы, помогающие им вести паразитическое существование. Они способны длительно выдерживать замораживание и высушивание. Попасть в организм человека они могут с немытыми и недостаточно обработанными продуктами питания, с грязными руками и другими предметами, например, грибы C.Parapsilosis инфицируют раны при проникновении в них инородных предметов, включая и непростерилизованные медицинские инструменты, а грибы C.Glabrata с мочевыми или внутривенными катетерами. Чаще всего происходит инфицирование грибами вида C.Albicans, причем с первых минут жизни младенца. Такое случается во время родов, если влагалище роженицы заселено этими микробами. Есть также предположение, что C.Albicans проникает в тело малыша еще на стадии эмбриона, так как грибы неоднократно обнаруживались в околоплодных водах. Если роженица входит в тот небольшой процент людей, не являющихся носителями грибов, ее малыш в течение первых лет жизни может заразиться ими через соску, игрушки и так далее. Паниковать из-за этого не стоит, так как кандиды, попав в организм своего хозяина, ведут себя смирно, даже помогают ему, контролируя рост других патогенов.
Когда инфицирование грибами Кандида становится заболеванием
Человек может быть носителем этих микробов всю жизнь, оставаясь при этом полностью здоровым. Грибы рода Кандида становятся патогенными, только когда их размножение выходит из-под контроля. Причины:
— обострение хронических болезней;
— гипо- или авитаминоз;
— длительное лечение антибиотиками;
Основной причиной, вызывающей кандидоз, является низкий иммунитет. Это состояние может появиться во многих ситуациях, включая плохое питание, неблагоприятные условия проживания, частые стрессы.
Кроме того, внезапный рост грибов рода Кандида происходит при следующих сопутствующих заболеваниях:
— СПИД (или ВИЧ-инфицирование);
— болезни мочеполовой системы;
— некоторые болезни крови;
Факторы патогенности
Размеры одного гриба рода Кандида составляют всего 2-5 мкм, поэтому рассмотреть их можно только в микроскоп. Те белые или желтовато-сероватые пленочки, которые вырастают на агаре или налет, видимый на пораженных участках тела – это целые колонии грибов, насчитывающие сотни тысяч отдельных микроорганизмов. Попав в организм хозяина, как ведут себя грибы рода Кандида? Исследования микробиологов показали, что каждый гриб стремится начать адгезию, то есть, плотно сцепиться, можно сказать, врасти в эпителиальные клетки человека. Это микробам удается тем легче, чем ниже иммунитет их жертвы, и чем выше у нее эндокринные нарушения. Самый активный по части сцепления гриб вида C.Albicans. Попав на слизистые, он адгезируется в 100% случаев. Самый пассивный гриб вида C.Krusei. Он может вообще не закрепиться, то есть инфицирования не происходит. Помогают грибам внедряться поверхностные белки, поверхностные протеины и некоторые молекулы, например, полисахариды и гликопротеиды, а во рту молекулы слюны. Вообще, Кандиды являются гликогенофилами (любят гликоген), поэтому чаще всего колонизируют ткани, где его содержится много, например, слизистые влагалища и ротовой полости. При возникновении молочницы грибы рода Кандида в мазке, взятом из этих органов, обнаруживаются с высокой вероятностью, что дает возможность безошибочно поставить диагноз.
На начальном этапе адгезии грибы находятся в дрожжевой форме, но быстро перестраиваются, образуя длинные нити (гифы), которые легче проникают в поврежденные клетки хозяина, а фагоцитозу лейкоцитов подвержены меньше.
Закрепившись и освоившись, паразиты в процессе своей жизнедеятельности выделяют в организм хозяина различные яды:
— кандидотоксин (белок, действующий на базофилы и тучные клетки и вызывающий псевдоаллергическую реакцию);
— 6 типов низкомолекулярных токсинов (повышают проницаемость сосудов, снижают артериальное давление);
— липидные токсины (вызывают местную лейкоцитарную реакцию и приводят к появлению грануляционной ткани).
Кандидоз у детей
Как отмечено выше, грудные дети инфицируются кандидами либо в утробе матери, либо при родах в момент прохождения родовых путей. В дальнейшем гриб может попасть младенцу в ротовую полость с плохо обработанной соской, погремушками, с сосков инфицированной матери. Симптомы того, что малыш заразился молочницей, следующие:
— белый, похожий на творожок налет на язычке, на внутренней поверхности десенок и щечек;
Без лечения гриб продолжает расселяться и вскоре появляется и на губах младенца.
Грибы рода Кандида в кишечнике проявляются симптомами дисбактериоза, такими как:
Понос у грудничков опасен тем, что влечет за собой быстрое обезвоживание, поэтому больной ребенок подлежит госпитализации. Только в условиях стационара можно оказать ему необходимое лечение (капельницы), чтобы предотвратить потерю жидкости.
Кроме органов ЖКТ и ротовой полости, молочница у малышей может проявляться на коже. В этом случае появляются не белые, а красные пятна, похожие на опрелости. Ребенок становится очень капризным, так как любые касания эрозий причиняют ему страдания. Чаще всего кожный кандидоз у грудничков появляется в складочках на ножках, на ягодицах и в области паха. Предшествуют этому опрелости, нахождение в памперсе слишком длительное время, плохая гигиена и неподходящая (синтетическая, слишком тесная) одежда.
Лечение детского кандидоза
Если грибы рода Кандида начали патогенный процесс в ротовой полости ребенка, лечение, как правило, проводят местно. Заключается оно в обработке мест, где наблюдается белый налет, специальными препаратами. Раньше врачи приписывали смазывать ребенку рот зеленкой. Это лекарство хорошо помогает, но сушит слизистые. Сейчас применяют «Акридерм», «Фукорцин», растворы буры в глицерине.
В целях профилактики нужно в первые месяцы жизни грудничка кипятить соски и бутылочки, мыть погремушки. Мама должна перед кормлением обрабатывать соски противогрибковыми препаратами.
При симптомах дисбактериоза сдают кал грудничка на бакпосев. Считается, что грибы рода Кандида в кале у детей возрастом до 12 месяцев могут присутствовать в количествах не более 103КОЕ/г, а старше 12 месяцев в количестве 104КОЕ/г. Если показатель превышен, назначают препараты, восстанавливающие микрофлору и укрепляющие иммунитет.
При кандидозе кожи пораженные участки смазывают противогрибковыми мазями — нистатиновой, левориновой. Очень полезно купать ребенка с добавлением в воду отвара череды, календулы, ромашки. Все белье и пеленки необходимо проглаживать, а памперсы менять достаточно часто, не дожидаясь их полного наполнения.
Если вышеуказанные методы лечения не помогают, ребенку проводят дополнительное обследование и назначают противогрибковую терапию.
Кандидоз у женщин и мужчин
У взрослых грибы Кандида могут, как и у детей, инфицировать ротовую полость, кожу, кишечник. Кандидоз во рту проявляется творожистым налетом, захватывающим язык, десна, нёбо, внутреннюю сторону щек и сопровождается болезненными ощущениями. Иногда слизистые изъязвляются. Кандидоз на коже характерен красными пятнами в местах внедрения гриба (под мышками, под грудями у женщин, в паху, реже под коленками). Эти пятна зудят и шелушатся, а при расчесах изъязвляются.
— белые (как кислое молоко) влагалищные выделения;
— зуд, не проходящий, а, наоборот, усиливающийся после подмывания и по утрам;
— неприятный запах нижнего белья;
— боль при половом акте.
Самый показательный симптом – грибы рода Кандида в мазке, взятом из влагалища.
Без лечения признаки заболевания усугубляются. Появляются боли не только при половом акте, но и при каждом мочеиспускании, слизистая влагалища отекает, изъязвляется, выделения становятся более густыми.
У мужчин инфицирование кандидой называется баланопоститом. Симптомы:
— выделения творожистого вида из полового органа;
— зуд, боли при мочеиспускании;
— болезненность полового акта.
Кроме мочеполовой системы, грибы Кандида паразитируют на наружных органах людей. Инфицирование ногтей называется «онихия», а приногтевого валика — «паранихия». Причинами этих заболеваний могут стать заусеницы, выполнение маникюра инфицированными инструментами.
Анализ на грибы рода Кандида
Наличие кандидоза устанавливают по результатам таких исследований:
— мазок из ротовой полости либо влагалища;
Дополнительно доктор может назначить анализы мочи и крови.
Если мазок планируют брать из влагалища и/или уретры, не разрешается перед этим подмываться, а мочиться можно только за 2 часа до взятия мазка, не позже. Если мазок планируют брать изо рта, запрещается перед этим чистить зубы.
Для проведения посева используют кал, мокроты, мочу, соскобы с пораженных участков кожи и слизистых. Через трое суток получают ответ, есть или нет в материале грибы рода Кандида. Норма – это отрицательный результат. Если анализы подтвердят наличие грибка, определяют его вид и чувствительность к медпрепаратам.
Анализ ИФА называется иммуноферментным. Он помогает выявить антитела к грибку и отследить динамику процесса. Материалом исследований для ИФА является кровь из вены. Как правило, его проводят совместно с бакпосевом.
Наиболее точным считается анализ ПЦР, что значит полимерно-цепная реакция молекул ДНК гриба. Он определяет наличие патогена даже на самой начальной стадии заболевания. Материалом для ПЦР служат мокроты, выделения, кровь.
Лечение
Если у пациента обнаружены грибы рода Кандида, лечение проводят медикаментозное. Внутрь выписывают:
Наружно используются мази:
— Свечи с пумафицином и другие средства, подавляющие рост грибка. Могут быть назначены и противовоспалительные мази.
Лечение беременных проводят только наружными средствами. Лишь в отдельных случаях назначается «Пумафицин» перорально.
При кандидозе мочеполовых путей проводится лечение обоих половых партнеров.
Дополнительно к противогрибковым препаратам назначаются витамины и другие средства, укрепляющие иммунитет.
Грибок кандида в небольшом количестве присутствует в каждом организме. Он живет на слизистых оболочках, внутренних органах, кожных покровах.
При нормальном состоянии организма никак себя не проявляет. При сбоях является причиной развития кандидоза. Что это и как проявляется?
Причины возникновения
Грибок кандида представляет собой одноклеточный микроорганизм. Клетки овальные или округлые. При нарушении микрофлоры начинают неконтролируемо размножаться.
Кандидоз (молочница) является одним из самых распространенных заболеваний. Чаще встречается у женщин в виду более частого снижения иммунитета. Поэтому их организм более подвержен различным недугам.
Почему возникает кандидоз у человека? Основной причиной размножения грибка кандида является снижение иммунитета. На это влияют многие факторы.
Факторы:
- Изменения в гормональном фоне,
- Беременность,
- Прием антибактериальных лекарственных средств долгое время,
- Постоянные депрессии, стрессы,
- Недостаток витаминов в организме,
- Наличие вредных привычек,
- Болезни инфекционного характера,
- Сахарный диабет,
- Младенческий или старческий возраст,
- Терапия препаратами, подавляющими иммунитет, при онкологических заболеваниях,
- Применение кремов и мазей со стероидами в составе,
- Половой акт с болеющим человеком,
- Наличие злокачественных образований.